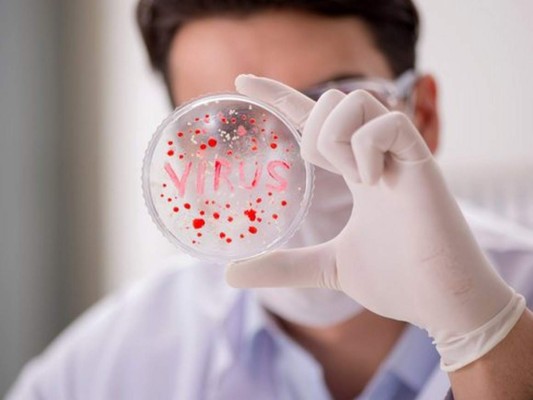
15 datos sobre los ensayos clínicos de vacunas contra coronavirus

15 datos sobre los ensayos clínicos de vacunas contra coronavirus
-
 1.'Las vacunas que hay en marcha están en sus primeras fases, algunas son prometedoras, pero tienen que ser eficaces y seguras, y tener capacidad de producción suficiente para las necesidades globales, así que será un periodo largo': Fernando Simón, director del Centro de Coordinación de Alertas y Emergencias sanitarias. “Que existan no quiere decir que estén disponibles”, añadió. 18/03/2020 - 00:001 / 15
1.'Las vacunas que hay en marcha están en sus primeras fases, algunas son prometedoras, pero tienen que ser eficaces y seguras, y tener capacidad de producción suficiente para las necesidades globales, así que será un periodo largo': Fernando Simón, director del Centro de Coordinación de Alertas y Emergencias sanitarias. “Que existan no quiere decir que estén disponibles”, añadió. 18/03/2020 - 00:001 / 15 -
 2. Las dos vacunas que están más avanzadas son las que están desarrollando China y Estados Unidos. El Ministerio de Defensa ha confirmado esta semana que su primer prototipo de vacuna contra el coronavirus ya está listo para realizar ensayos clínicos. 18/03/2020 - 00:002 / 15
2. Las dos vacunas que están más avanzadas son las que están desarrollando China y Estados Unidos. El Ministerio de Defensa ha confirmado esta semana que su primer prototipo de vacuna contra el coronavirus ya está listo para realizar ensayos clínicos. 18/03/2020 - 00:002 / 15 -
 3. Este proyecto ha sido desarrollado por una empresa privada, CanSino Biologics, localizada en Tianjin –ciudad portuaria cercana a la capital–, en colaboración con la Academia Militar de Ciencias Médicas. Los responsables del proyecto buscan voluntarios para llevar a cabo las primeras pruebas en seres humanos: los candidatos deben ser sujetos sanos, con edades comprendidas entre los 18 y los 60 años y no haber padecido la dolencia en el pasado. No obstante, aun en caso de que los ensayos fueran exitosos, la vacuna no estaría lista para su comercialización hasta dentro de un mínimo de 12 meses. 18/03/2020 - 00:003 / 15
3. Este proyecto ha sido desarrollado por una empresa privada, CanSino Biologics, localizada en Tianjin –ciudad portuaria cercana a la capital–, en colaboración con la Academia Militar de Ciencias Médicas. Los responsables del proyecto buscan voluntarios para llevar a cabo las primeras pruebas en seres humanos: los candidatos deben ser sujetos sanos, con edades comprendidas entre los 18 y los 60 años y no haber padecido la dolencia en el pasado. No obstante, aun en caso de que los ensayos fueran exitosos, la vacuna no estaría lista para su comercialización hasta dentro de un mínimo de 12 meses. 18/03/2020 - 00:003 / 15 -
 4. El resultado es una vacuna de subunidad, una fórmula de nueva generación que solo contiene ciertos antígenos específicos sin patógenos, por lo que es contemplada como más segura que las técnicas tradicionales. “La vacuna no tiene sustancias infecciosas, es muy segura y estable y requiere una sola inoculación”, explicaba el Centro para el Control y Prevención de Enfermedades de Hubei en su reclamo en busca de voluntarios. 18/03/2020 - 00:004 / 15
4. El resultado es una vacuna de subunidad, una fórmula de nueva generación que solo contiene ciertos antígenos específicos sin patógenos, por lo que es contemplada como más segura que las técnicas tradicionales. “La vacuna no tiene sustancias infecciosas, es muy segura y estable y requiere una sola inoculación”, explicaba el Centro para el Control y Prevención de Enfermedades de Hubei en su reclamo en busca de voluntarios. 18/03/2020 - 00:004 / 15 -
 5. Estados Unidos comenzó la primera fase de los ensayos clínicos de su propia vacuna experimental. Se trata de un proyecto financiado por el Instituto Nacional de Salud y desarrollado por la biotecnológica Moderna. 18/03/2020 - 00:005 / 15
5. Estados Unidos comenzó la primera fase de los ensayos clínicos de su propia vacuna experimental. Se trata de un proyecto financiado por el Instituto Nacional de Salud y desarrollado por la biotecnológica Moderna. 18/03/2020 - 00:005 / 15 -
 6. A diferencia de la alternativa china, EEUU emplea una tecnología conocida como ARN mensajero (ARNm), la cual copia el código genético del virus en lugar de transmitir una versión atenuada del propio virus. Hasta la fecha, ninguna vacuna que emplee la fórmula ARNm ha sido aprobada para su uso en seres humanos. 18/03/2020 - 00:006 / 15
6. A diferencia de la alternativa china, EEUU emplea una tecnología conocida como ARN mensajero (ARNm), la cual copia el código genético del virus en lugar de transmitir una versión atenuada del propio virus. Hasta la fecha, ninguna vacuna que emplee la fórmula ARNm ha sido aprobada para su uso en seres humanos. 18/03/2020 - 00:006 / 15 -
 7. La vacuna consiste en dos pinchazos en el brazo, uno ahora y otro dentro de 28 días. El objetivo es observar la seguridad de diferentes dosis. Se espera que el ensayo haya terminado en unas seis semanas.
7. La vacuna consiste en dos pinchazos en el brazo, uno ahora y otro dentro de 28 días. El objetivo es observar la seguridad de diferentes dosis. Se espera que el ensayo haya terminado en unas seis semanas.
18/03/2020 - 00:007 / 15 -
 8. Hasta 1,000 científicos chinos están participando en esta campaña nacional, con nueve proyectos en marcha recurriendo a cinco técnicas diferentes, como vacunas inactivadas, de vector viral o genéticas, las cuales se encuentran en diferentes fases de desarrollo. De esas nueve alternativas, el proyecto de CanSino y la Academia Militar de Ciencias Médicas es la más avanzada. 18/03/2020 - 00:008 / 15
8. Hasta 1,000 científicos chinos están participando en esta campaña nacional, con nueve proyectos en marcha recurriendo a cinco técnicas diferentes, como vacunas inactivadas, de vector viral o genéticas, las cuales se encuentran en diferentes fases de desarrollo. De esas nueve alternativas, el proyecto de CanSino y la Academia Militar de Ciencias Médicas es la más avanzada. 18/03/2020 - 00:008 / 15 -
 9. China también cuenta con un prototipo de vacuna ARNm, al estilo estadounidense, en la cual investigan un equipo conjunto del Centro Chino para el Control y Prevención de Enfermedades, la Universidad Tongji de Shanghái y la empresa Stermina. 18/03/2020 - 00:009 / 15
9. China también cuenta con un prototipo de vacuna ARNm, al estilo estadounidense, en la cual investigan un equipo conjunto del Centro Chino para el Control y Prevención de Enfermedades, la Universidad Tongji de Shanghái y la empresa Stermina. 18/03/2020 - 00:009 / 15 -
 10. Esta alternativa está siendo testada en animales y se espera que alcance la fase clínica a mediados de abril. “La capacidad de investigación y desarrollo de vacunas en China es, en términos generales, una de las más avanzadas del mundo”, afirmaba un experto en control de calidad de productos biológicos e investigador en la Academia China de Ciencias Sociales. 18/03/2020 - 00:0010 / 15
10. Esta alternativa está siendo testada en animales y se espera que alcance la fase clínica a mediados de abril. “La capacidad de investigación y desarrollo de vacunas en China es, en términos generales, una de las más avanzadas del mundo”, afirmaba un experto en control de calidad de productos biológicos e investigador en la Academia China de Ciencias Sociales. 18/03/2020 - 00:0010 / 15 -
 11. En los esfuerzos para frenar el coronavirus, hay parte del camino hecho por la investigación sobre virus como el MERS o el SARS, que son de la misma familia, pero hay cuestiones como las pruebas de seguridad que requieren tiempo para ver los efectos del nuevo fármaco.
11. En los esfuerzos para frenar el coronavirus, hay parte del camino hecho por la investigación sobre virus como el MERS o el SARS, que son de la misma familia, pero hay cuestiones como las pruebas de seguridad que requieren tiempo para ver los efectos del nuevo fármaco.
18/03/2020 - 00:0011 / 15 -
 12. Un laboratorio de la Universidad de Queensland (Australia) también tiene una posible vacuna que comenzará a probarse en humanos en los próximos meses. 18/03/2020 - 00:0012 / 15
12. Un laboratorio de la Universidad de Queensland (Australia) también tiene una posible vacuna que comenzará a probarse en humanos en los próximos meses. 18/03/2020 - 00:0012 / 15 -
 13. El propio Gobierno español ha dedicado 30 millones de euros a estas tareas. En total, se estima que llevar hasta el final de los ensayos clínicos de las tres vacunas más prometedoras para la CEPI requerirá una inversión de 1,800 millones de euros. 18/03/2020 - 00:0013 / 15
13. El propio Gobierno español ha dedicado 30 millones de euros a estas tareas. En total, se estima que llevar hasta el final de los ensayos clínicos de las tres vacunas más prometedoras para la CEPI requerirá una inversión de 1,800 millones de euros. 18/03/2020 - 00:0013 / 15 -
 14. España, por su parte, también está luchando por tener su propia vacuna. El Gobierno anunció una inversión de 29.65 millones de euros para investigaciones sobre el nuevo coronavirus como una de las medidas económicas de urgencia contra la Covid 19.
14. España, por su parte, también está luchando por tener su propia vacuna. El Gobierno anunció una inversión de 29.65 millones de euros para investigaciones sobre el nuevo coronavirus como una de las medidas económicas de urgencia contra la Covid 19.
18/03/2020 - 00:0014 / 15 -
 15. La empresa CureVac trabaja junto con el instituto Paul Ehrlich de vacunas y biomedicina y calcula que a principios de verano tendrán lista una vacuna experimental, que podrían empezar a probar en humanos.
15. La empresa CureVac trabaja junto con el instituto Paul Ehrlich de vacunas y biomedicina y calcula que a principios de verano tendrán lista una vacuna experimental, que podrían empezar a probar en humanos.
18/03/2020 - 00:0015 / 15